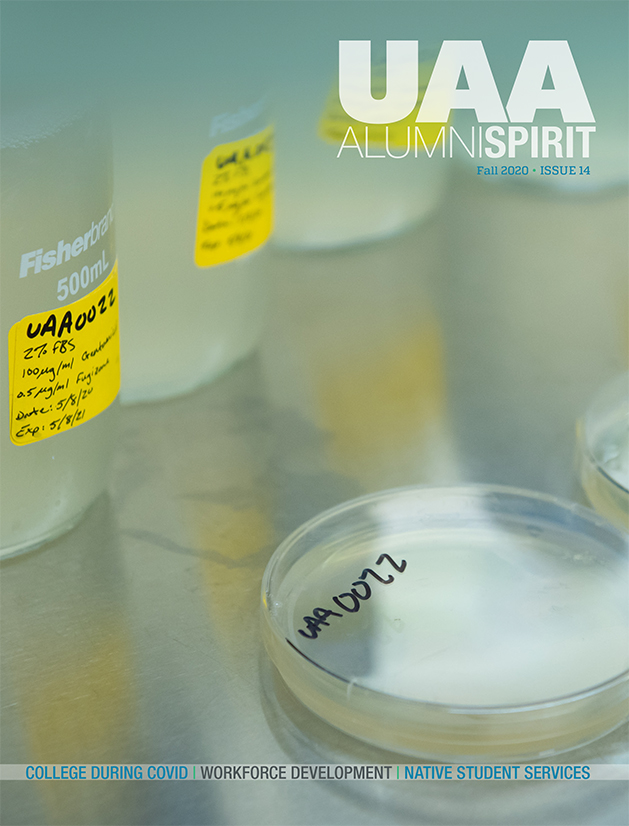

Alumni Spirit Magazine
Current Issue: Spring/Summer 2023
Past Digital Issues
Past PDF Issues
- UAA Alumni Spirit – Fall 2018 Publication (PDF)
- UAA Alumni Spirit – Spring 2018 Publication (PDF)
- UAA Alumni Spirit – Fall 2017 Publication (PDF)
- UAA Alumni Spirit – Spring 2017 Publication (PDF)
- UAA Alumni Spirit – Fall 2016 Publication (PDF)
- UAA Alumni Spirit – Spring 2016 Publication (PDF)
- UAA Alumni Spirit – Fall 2015 Publication (PDF)
- UAA Alumni Spirit – Spring 2015 Publication (PDF)
- UAA Alumni Spirit – Fall 2014 Publication (PDF)
- UAA Alumni Spirit – Spring 2014 Publication (PDF)
Subscribe
Sign up to be notified when the next issue is available.
Update your information to stay connected with UAA.